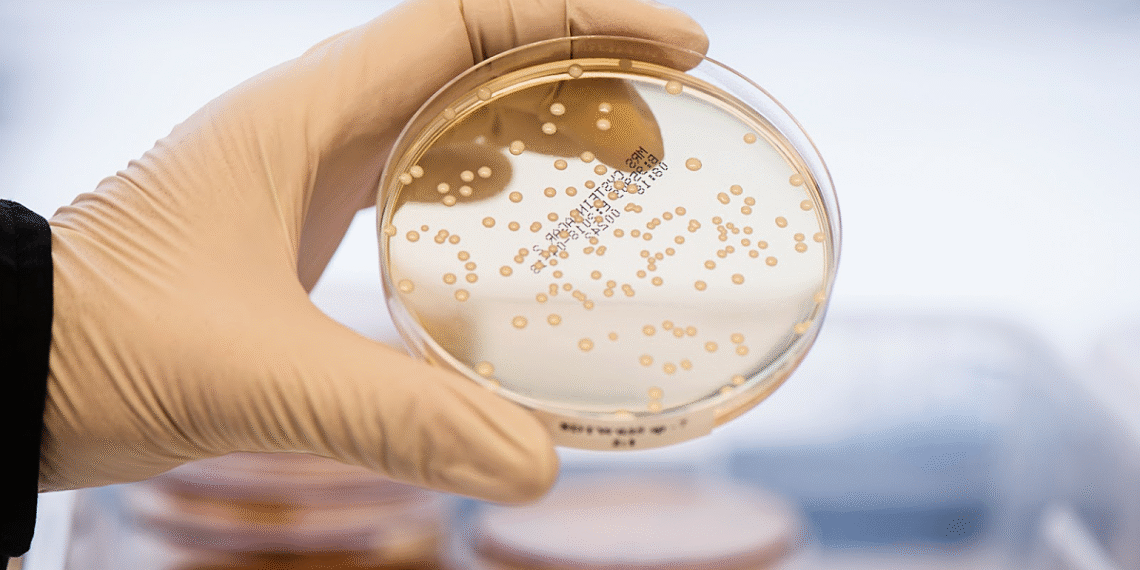
image2113805214extractword1out 7670 9334 1757930708.png

Men vi sinh BioGaia tạo ra reuterin, acid lactic và acetic, giúp ức chế vi khuẩn có hại, nuôi dưỡng lợi khuẩn, xây dựng hệ vi sinh đường ruột cân bằng, khỏe mạnh.
Men vi sinh BioGaia Protectis ra đời tại Thụy Điển, một trong những quốc gia có tiêu chuẩn y tế khắt khe nhất thế giới. Mỗi sản phẩm BioGaia là kết quả của nhiều thập kỷ nghiên cứu với quy trình sản xuất nghiêm ngặt, được kiểm soát từ khâu nghiên cứu đến phân phối.

Các nhà khoa học làm việc trong phòng nghiên cứu của BioGaia tại Eslov, Thụy Điển. Ảnh: Biogaiagroup
Trong suốt 35 năm, với mạng lưới hợp tác cùng hơn 50 viện nghiên cứu trên toàn cầu, BioGaia đã phát triển thành công nhiều các sản phẩm men vi sinh. Đặc biệt, để cho ra đời dòng sản phẩm thực phẩm bảo vệ sức khỏe BioGaia Protectis Baby Drops là hơn 200.000 giờ nghiên cứu của các chuyên gia BioGaia. Nhờ vậy, các sản phẩm có độ an toàn cao và có thể sử dụng được cho các đối tượng nhạy cảm như trẻ sơ sinh và cả trẻ sinh non.
Chủng lợi khuẩn độc quyền Lactobacillus reuteri Protectis là “chìa khóa” tạo nên giá trị khác biệt và hiệu quả của các sản phẩm đến từ thương hiệu BioGaia. Theo Trung tâm Thông tin Công nghệ sinh học Quốc gia Mỹ, đây không chỉ là một chủng lợi khuẩn thông thường, mà là một trong những chủng probiotic được nghiên cứu kỹ lưỡng nhất trên thế giới.
L. reuteri Protectis là chủng men vi sinh được chứng minh có cơ chế tác động đa chiều, mang lại sự bảo vệ toàn diện cho hệ tiêu hóa. Chủng này tạo ra một môi trường đường ruột lý tưởng bằng cách sản sinh các chất kháng khuẩn tự nhiên như reuterin, acid lactic và acid acetic. Từ đó giúp tiêu diệt và ức chế sự phát triển của vi khuẩn có hại, đồng thời tạo điều kiện cho các lợi khuẩn khác phát triển, xây dựng một hệ vi sinh vật khỏe mạnh và cân bằng.

Đĩa petri có chứa các khuẩn lạc vi khuẩn đã được nuôi cấy. Ảnh: Biogaiagroup
Với khả năng tác động tích cực lên nhu động ruột và cơ chế đặc biệt giúp chặn thụ thể đau TRPV-1 thông qua việc phóng thích các chất dẫn truyền thần kinh, chủng men tiêu hóa này góp phần làm dịu các cảm giác khó chịu ở đường tiêu hóa.
L. reuteri Protectis cũng giúp củng cố và thắt chặt hàng rào biểu mô, tăng cường sự toàn vẹn của niêm mạc ruột.
Chất lượng và hiệu quả của L. reuteri Protectis không chỉ được chứng minh qua hơn 180 nghiên cứu lâm sàng mà còn được công nhận và khuyến nghị bởi các tổ chức y khoa hàng đầu thế giới như: Tổ chức Tiêu hóa Thế giới (WGO); Hiệp hội Tiêu hóa, Gan mật và Dinh dưỡng Nhi khoa châu Âu (Espghan)…

Nhà khoa học đang dùng pipet nhỏ dung dịch vào đĩa petri trong phòng thí nghiệm. Ảnh: Biogaiagroup
Đặc biệt, L. reuteri Protectis đã hai lần được Cục quản lý Thực phẩm và Dược phẩm Mỹ (FDA) chứng nhận an toàn ở cấp cao nhất – GRAS (Generally Recognized As Safe), chứng nhận số 254 và 410 khẳng định sự an toàn tuyệt đối khi sử dụng lâu dài cho mọi lứa tuổi.
“Những dữ liệu lâm sàng này là minh chứng cho hiệu quả của sản phẩm và chìa khóa giúp BioGaia nhận được niềm tin và tình cảm của nhiều chuyên gia và khách hàng”, đại diện nhãn hàng cho biết.
Hành trình 10 năm tại thị trường Việt Nam của BioGaia không chỉ là hành trình mang đến các sản phẩm chất lượng cho người tiêu dùng. Đó còn là hành trình tiên phong trong việc giáo dục thị trường về tầm quan trọng của probiotics nói riêng và chăm sóc hệ tiêu hóa nói chung.

Hội nghị khoa học về Probiotics khu vực châu Á – Thái Bình Dương tổ chức bởi BioGaia tại Đà Nẵng. Ảnh: BioVagen
Trước ngưỡng cửa quan trọng của Việt Nam, BioGaia cam kết sẽ tiếp tục đầu tư mạnh mẽ vào nghiên cứu và phát triển, cải tiến để duy trì chất lượng sản phẩm ở mức cao nhất, góp phần mang đến những giải pháp chăm sóc sức khỏe dựa trên nền tảng khoa học, đồng hành cùng sự phát triển khỏe mạnh của thế hệ tương lai.
Thế Đan